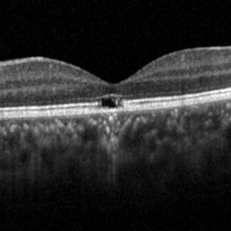

-
 Chronic Retinal Detachment with Proliferative Vitreoretinopathy
Chronic Retinal Detachment with Proliferative Vitreoretinopathy
Jan 25 2024 by Isaac Agranoff
Widefield fundus photography of a 24 year old male presenting with subtotal retinal detachment with circumferential anterior proliferative vitreoretinopathy. The detachment is bullous inferiorly with atrophic retina and subretinal bands. There are also scattered patches of lattice with atrophic holes and associated detachment in the periphery. Patient presented with flashes for 2 years with worsening vision over the past 6-8 months, measured at 20/100 ph 20/60 OS.
Photographer: Isaac Agranoff, Ashley Rigdon
Imaging device: Optos California
Condition/keywords: atrophic hole, chronic retinal detachment, lattice degeneration, proliferative vitreoretinopathy (PVR), subretinal bands
-
 Cytomegalovirus Retinitis
Cytomegalovirus Retinitis
Jan 29 2024 by Isaac Agranoff
Widefield fundus photograph of a 73 year old male with Cytomegalovirus Retinitis. Patient presented with CMV retinitis after noticing visual changes the last 7 months. Vision was measured in office at HM.
Photographer: Isaac Agranoff
Imaging device: Optos California
Condition/keywords: branch retinal vein occlusion (BRVO), central retinal artery occlusion, CMV retinitis, cytomegalovirus (CMV)
-
 Branch Retinal Vein Occlusion with Retinal Neovascularization
Branch Retinal Vein Occlusion with Retinal Neovascularization
Mar 21 2024 by Isaac Agranoff
Fundus angiography photograph of a 63 year old male presenting with worsening blurry vision OD for 4 years with new transient floaters (vision 20/160 PH 20/60). Fluorescein angiography revealed significant capillary non-perfusion corresponding to the area, with peripheral vascular remodeling. Physician recommended anti-VEGF therapy and FA-guided supplemental PRP given the size of the NVE.
Photographer: Isaac Agranoff
Imaging device: Optos California
Condition/keywords: branch retinal vein occlusion (BRVO), EYLEA, Neovascularisation elsewhere (NVE), Optos
-
 Retinitis Pigmentosa Bullseye Appearing Autofluorescence
Retinitis Pigmentosa Bullseye Appearing Autofluorescence
Feb 4 2025 by Isaac Agranoff
Fundus Autofluorescence of a 14-year-old boy with suspected RP. ERG performed afterwards was almost flat. VA measured at 20/30 but with extensive constriction of confrontational visual fields. Currently awaiting genetic testing.
Photographer: Isaac Agranoff
Imaging device: Optos California
Condition/keywords: fundus autofluorescence (FAF), retinitis pigmentosa, RP
-
Solar Retinopathy
Solar Retinopathy
Apr 1 2025 by Isaac Agranoff
OCT scan of 18-year-old male presenting with 20/40 BCVA OU and bilateral focal outer retinal subfoveal defects. Patient reported long-term history of frequent sungazing, has stopped within past 6-9 months.
Photographer: Isaac Agranoff
Imaging device: Heidelberg Spectralis
Condition/keywords: solar retinopathy

A project from the American Society of Retina Specialists